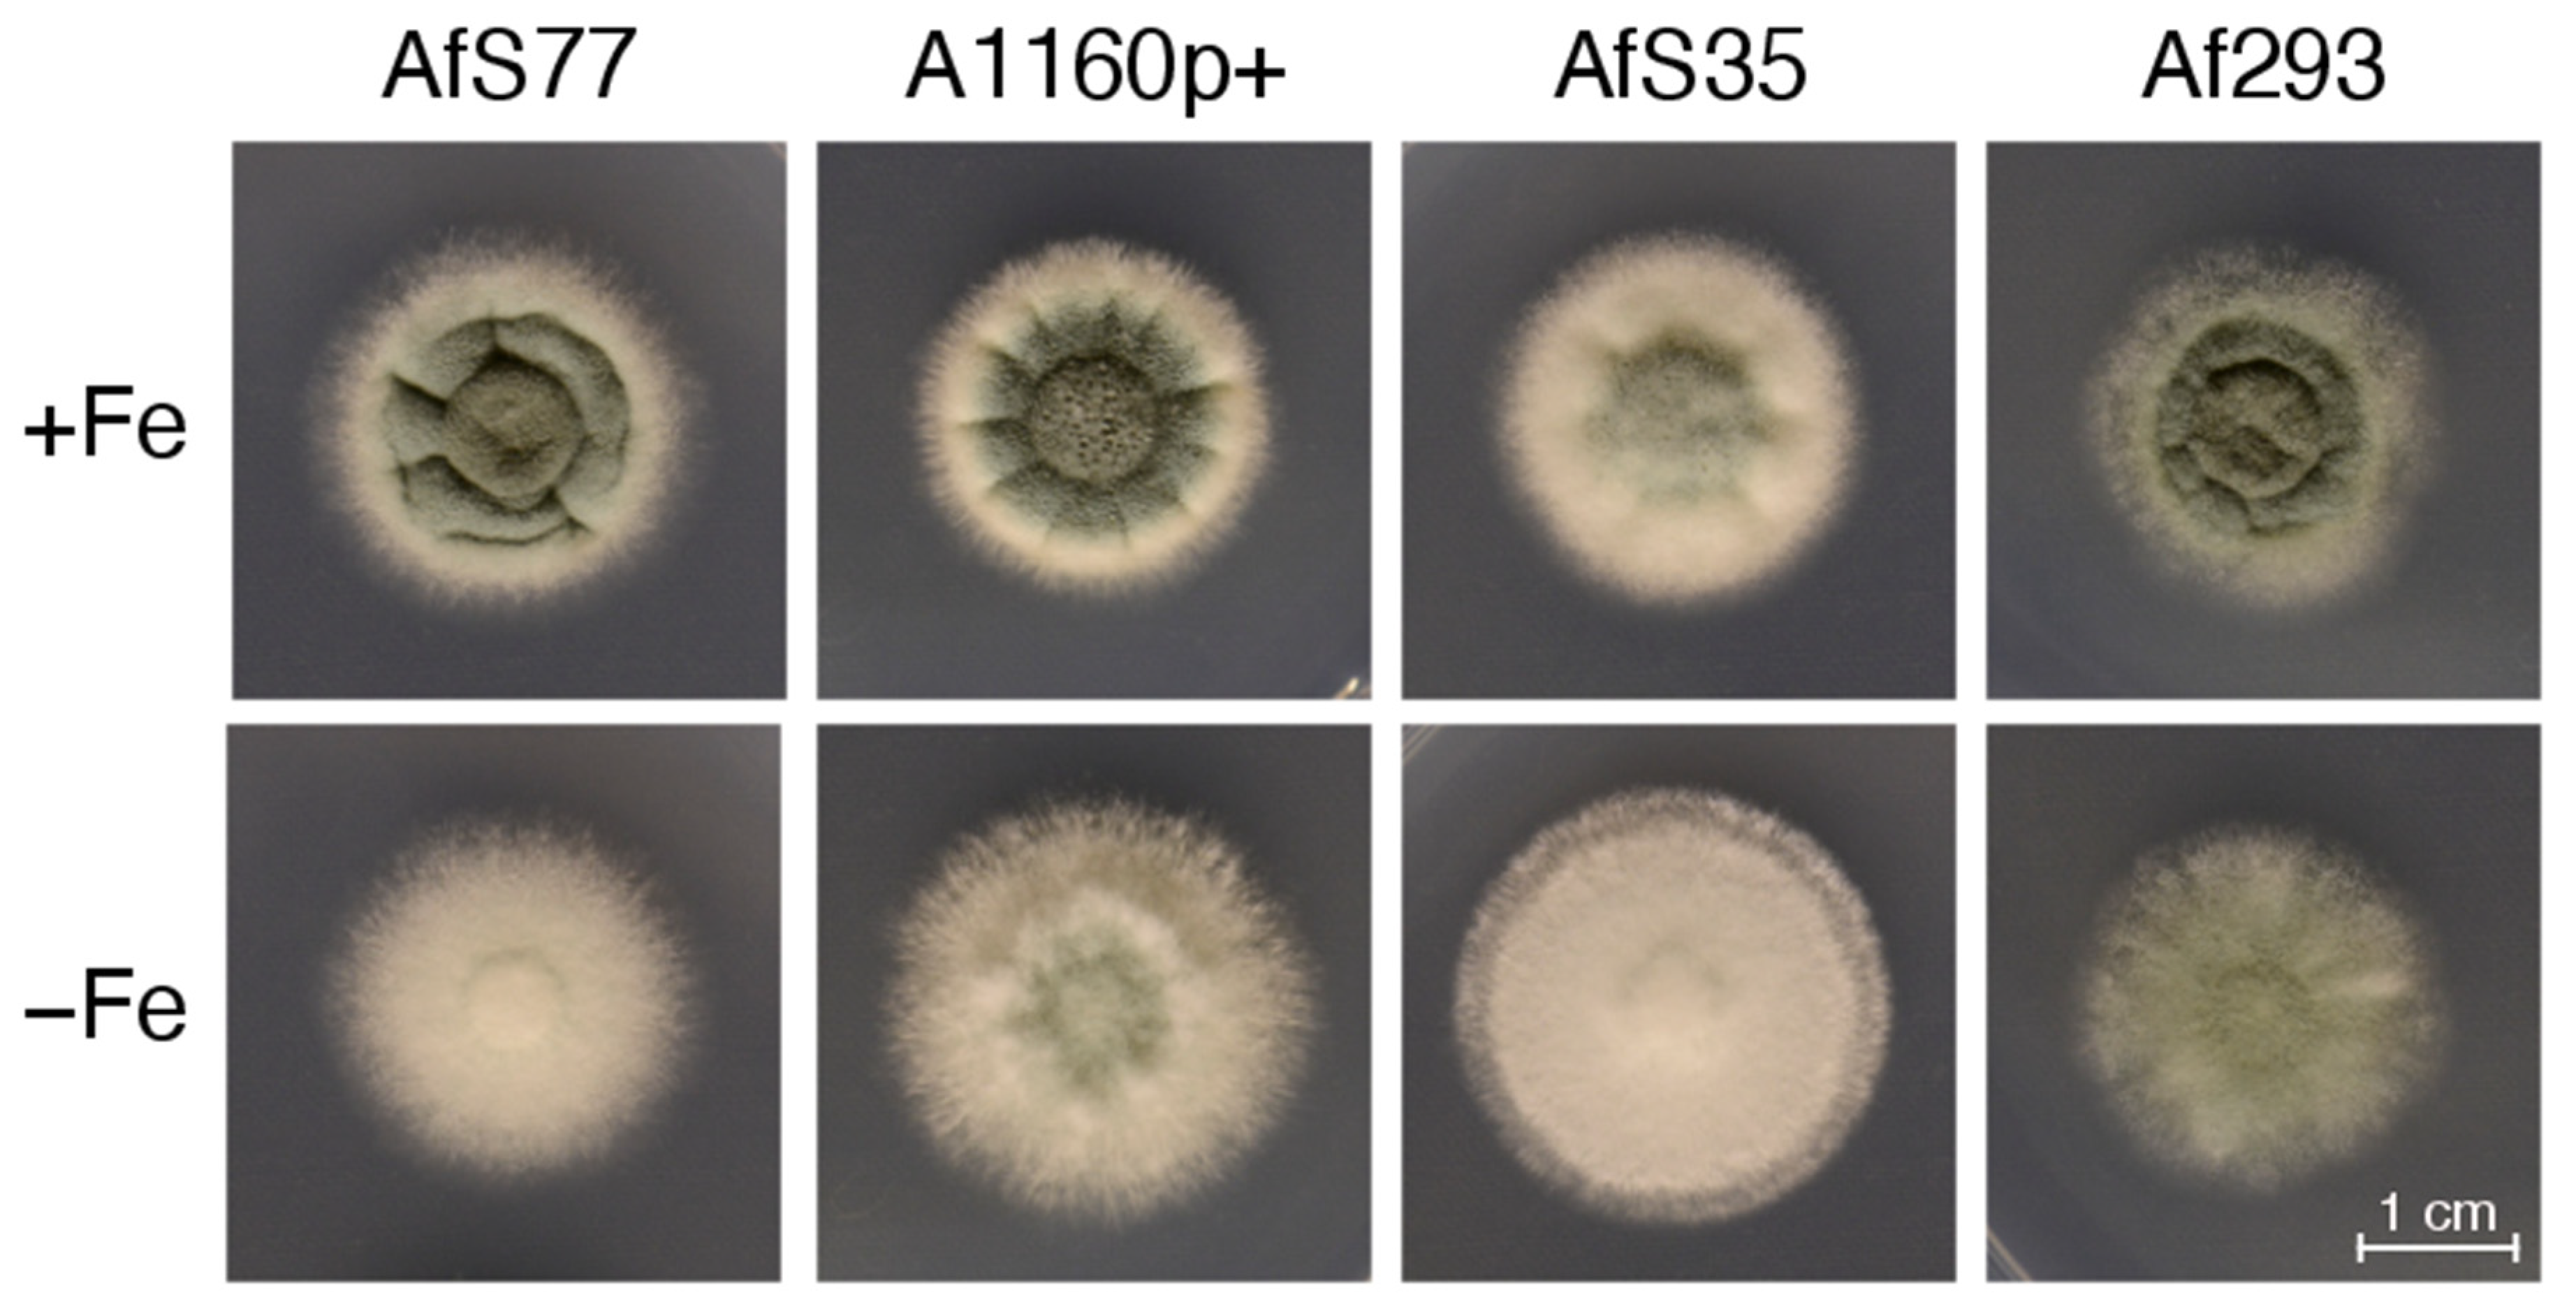
Jof 08 01013 g011 Jof 08 01013 g011

Online Biomass Monitoring Enables Characterization of the Growth Pattern of Aspergillus fumigatus in Liquid Shake Conditions
Abstract
1. Introduction
2. Materials and Methods
2.1. Fungal Strains and Growth Conditions
2.2. Determination of Protease Activity in Culture Supernatant
2.3. Determination of Pellet Morphology and Size Distribution
2.4. Presentation of CGQ-Mediated Growth Monitoring and Statistics
3. Results and Discussion
3.1. CGQ Characterizes the Growth Curve of A. fumigatus during Iron Sufficiency and Iron Starvation
3.2. CGQ Provides Reproducible Growth Curves
3.3. CGQ Portrays Growth Differences due to Nitrogen Limitation
3.4. CGQ Delineates Growth Defects of A. fumigatus Mutant Strains Lacking Either HapX or SrbA
3.5. CGQ Displays Differences in Growth of Different A. fumigatus Laboratory Type Strains
4. Conclusions
Supplementary Materials
Author Contributions
Funding
Institutional Review Board Statement
Informed Consent Statement
Data Availability Statement
Acknowledgments
Conflicts of Interest
References
- Meyer, V.; Andersen, M.R.; Brakhage, A.A.; Braus, G.H.; Caddick, M.X.; Cairns, T.C.; de Vries, R.P.; Haarmann, T.; Hansen, K.; Hertz-Fowler, C.; et al. Current challenges of research on filamentous fungi in relation to human welfare and a sustainable bio-economy: A white paper. Fungal Biol. Biotechnol. 2016, 3, 6. [Google Scholar] [CrossRef]
- Yu, Y.; Hube, B.; Kämper, J.; Meyer, V.; Krappmann, S. When green and red mycology meet: Impressions from an interdisciplinary forum on virulence mechanisms of phyto- and human-pathogenic fungi. Virulence 2017, 8, 1435–1444. [Google Scholar] [CrossRef] [PubMed]
- Brown, G.D.; Denning, D.W.; Gow, N.A.R.; Levitz, S.M.; Netea, M.G.; White, T.C. Hidden killers: Human fungal infections. Sci. Transl. Med. 2012, 4, 165rv13. [Google Scholar] [CrossRef] [PubMed]
- Behera, B.C. Citric acid from Aspergillus niger: A comprehensive overview. Crit. Rev. Microbiol. 2020, 46, 727–749. [Google Scholar] [CrossRef]
- Bischof, R.H.; Ramoni, J.; Seiboth, B. Cellulases and beyond: The first 70 years of the enzyme producer Trichoderma reesei. Microb. Cell Fact. 2016, 15, 106. [Google Scholar] [CrossRef]
- Schmoll, M.; Dattenböck, C.; Carreras-Villaseñor, N.; Mendoza-Mendoza, A.; Tisch, D.; Alemán, M.I.; Baker, S.E.; Brown, C.; Cervantes-Badillo, M.G.; Cetz-Chel, J.; et al. The Genomes of Three Uneven Siblings: Footprints of the Lifestyles of Three Trichoderma Species. Microbiol. Mol. Biol. Rev. 2016, 80, 205–327. [Google Scholar] [CrossRef]
- Park, H.-S.; Yu, J.-H. Genetic control of asexual sporulation in filamentous fungi. Curr. Opin. Microbiol. 2012, 15, 669–677. [Google Scholar] [CrossRef]
- Latgé, J.-P.; Beauvais, A.; Chamilos, G. The Cell Wall of the Human Fungal Pathogen Aspergillus fumigatus: Biosynthesis, Organization, Immune Response, and Virulence. Annu. Rev. Microbiol. 2017, 71, 99–116. [Google Scholar] [CrossRef] [PubMed]
- Gow, N.A.R.; Latge, J.-P.; Munro, C.A. The Fungal Cell Wall: Structure, Biosynthesis, and Function. Microbiol. Spectr. 2017, 5, 3–5. [Google Scholar] [CrossRef]
- Lee, M.J.; Sheppard, D.C. Recent advances in the understanding of the Aspergillus fumigatus cell wall. J. Microbiol. 2016, 54, 232–242. [Google Scholar] [CrossRef]
- D’Enfert, C. Fungal Spore Germination: Insights from the Molecular Genetics of Aspergillus nidulans and Neurospora crassa. Fungal Genet. Biol. 1997, 21, 163–172. [Google Scholar] [CrossRef]
- Momany, M. Polarity in filamentous fungi: Establishment, maintenance and new axes. Curr. Opin. Microbiol. 2002, 5, 580–585. [Google Scholar] [CrossRef]
- Sheppard, D.C.; Howell, P.L. Biofilm Exopolysaccharides of Pathogenic Fungi: Lessons from Bacteria. J. Biol. Chem. 2016, 291, 12529–12537. [Google Scholar] [CrossRef]
- Loussert, C.; Schmitt, C.; Prevost, M.-C.; Balloy, V.; Fadel, E.; Philippe, B.; Kauffmann-Lacroix, C.; Latgé, J.P.; Beauvais, A. In vivo biofilm composition of Aspergillus fumigatus. Cell. Microbiol. 2010, 12, 405–410. [Google Scholar] [CrossRef] [PubMed]
- Fontaine, T.; Beauvais, A.; Loussert, C.; Thevenard, B.; Fulgsang, C.C.; Ohno, N.; Clavaud, C.; Prevost, M.-C.; Latgé, J.-P. Cell wall alpha1-3glucans induce the aggregation of germinating conidia of Aspergillus fumigatus. Fungal Genet. Biol. 2010, 47, 707–712. [Google Scholar] [CrossRef] [PubMed]
- Miyazawa, K.; Umeyama, T.; Hoshino, Y.; Abe, K.; Miyazaki, Y. Quantitative Monitoring of Mycelial Growth of Aspergillus fumigatus in Liquid Culture by Optical Density. Microbiol. Spectr. 2022, 10, e0006321. [Google Scholar] [CrossRef] [PubMed]
- Müller, H.; Barthel, L.; Schmideder, S.; Schütze, T.; Meyer, V.; Briesen, H. From spores to fungal pellets: A new high-throughput image analysis highlights the structural development of Aspergillus niger. Biotechnol. Bioeng. 2022, 119, 2011–2267. [Google Scholar] [CrossRef]
- Latgé, J.-P.; Chamilos, G. Aspergillus fumigatus and Aspergillosis in 2019. Clin. Microbiol. Rev. 2019, 33, e00140-18. [Google Scholar] [CrossRef]
- Bruder, S.; Reifenrath, M.; Thomik, T.; Boles, E.; Herzog, K. Parallelised online biomass monitoring in shake flasks enables efficient strain and carbon source dependent growth characterisation of Saccharomyces cerevisiae. Microb. Cell Fact. 2016, 15, 127. [Google Scholar] [CrossRef] [PubMed]
- Hartmann, T.; Dümig, M.; Jaber, B.M.; Szewczyk, E.; Olbermann, P.; Morschhäuser, J.; Krappmann, S. Validation of a self-excising marker in the human pathogen Aspergillus fumigatus by employing the beta-rec/six site-specific recombination system. Appl. Environ. Microbiol. 2010, 76, 6313–6317. [Google Scholar] [CrossRef]
- Schrettl, M.; Beckmann, N.; Varga, J.; Heinekamp, T.; Jacobsen, I.D.; Jöchl, C.; Moussa, T.A.; Wang, S.; Gsaller, F.; Blatzer, M.; et al. HapX-mediated adaption to iron starvation is crucial for virulence of Aspergillus fumigatus. PLoS Pathog. 2010, 6, e1001124. [Google Scholar] [CrossRef] [PubMed]
- Blatzer, M.; Barker, B.M.; Willger, S.D.; Beckmann, N.; Blosser, S.J.; Cornish, E.J.; Mazurie, A.; Grahl, N.; Haas, H.; Cramer, R.A. SREBP Coordinates Iron and Ergosterol Homeostasis to Mediate Triazole Drug and Hypoxia Responses in the Human Fungal Pathogen Aspergillus fumigatus. PLoS Genet. 2011, 7, e1002374. [Google Scholar] [CrossRef] [PubMed]
- Krappmann, S.; Sasse, C.; Braus, G.H. Gene targeting in Aspergillus fumigatus by homologous recombination is facilitated in a nonhomologous end-joining-deficient genetic background. Eukaryot. Cell 2006, 5, 212–215. [Google Scholar] [CrossRef] [PubMed]
- Bertuzzi, M.; van Rhijn, N.; Krappmann, S.; Bowyer, P.; Bromley, M.J.; Bignell, E.M. On the lineage of Aspergillus fumigatus isolates in common laboratory use. Med. Mycol. 2021, 59, 7–13. [Google Scholar] [CrossRef]
- Nierman, W.C.; Pain, A.; Anderson, M.J.; Wortman, J.R.; Kim, H.S.; Arroyo, J.; Berriman, M.; Abe, K.; Archer, D.B.; Bermejo, C.; et al. Genomic sequence of the pathogenic and allergenic filamentous fungus Aspergillus fumigatus. Nature 2005, 438, 1151–1156. [Google Scholar] [CrossRef] [PubMed]
- Pontecorvo, G.; Roper, J.A.; Hemmons, L.M.; MacDonald, K.D.; Bufton, A.W.J. The genetics of Aspergillus nidulans. Adv. Genet. 1953, 5, 141–238. [Google Scholar] [CrossRef] [PubMed]
- Bergmann, A.; Hartmann, T.; Cairns, T.; Bignell, E.M.; Krappmann, S. A regulator of Aspergillus fumigatus extracellular proteolytic activity is dispensable for virulence. Infect. Immun. 2009, 77, 4041–4050. [Google Scholar] [CrossRef] [PubMed]
- Cheung, A.L.; Ying, P.; Fischetti, V.A. A method to detect proteinase activity using unprocessed X-ray films. Anal. Biochem. 1991, 193, 20–23. [Google Scholar] [CrossRef]
- Schindelin, J.; Arganda-Carreras, I.; Frise, E.; Kaynig, V.; Longair, M.; Pietzsch, T.; Preibisch, S.; Rueden, C.; Saalfeld, S.; Schmid, B.; et al. Fiji: An open-source platform for biological-image analysis. Nat. Methods 2012, 9, 676–682. [Google Scholar] [CrossRef]
- Quantification of Fluorescence Spots Intensity along The Spot Area. Available online: https://forum.image.sc/t/quantification-of-fluorescence-spots-intensity-along-the-spot-area/21522 (accessed on 20 July 2022).
- R Core. Team R: A Language and Environment for Statistical Computing; R Foundation: Vienna, Austria, 2021. [Google Scholar]
- Wickham, H.; Averick, M.; Bryan, J.; Chang, W.; McGowan, L.D.; François, R.; Grolemund, G.; Hayes, A.; Henry, L.; Hester, J.; et al. Welcome to the tidyverse. J. Open Source Softw. 2019, 4, 1686. [Google Scholar] [CrossRef]
- Wickham, H. ggplot2: Elegant Graphics for Data Analysis; Taylor & Francis: Abingdon, UK, 2016. [Google Scholar]
- Kassambara, A. ggpubr: ‘ggplot2’ Based Publication Ready Plots. 2020. Available online: https://CRAN.R-project.org/package=ggpubr (accessed on 30 May 2022).
- Schauberger, P.; Walker, A. openxlsx: Read, Write and Edit xlsx Files. 2021. Available online: https://CRAN.R-project.org/package=openxlsx (accessed on 30 May 2022).
- Schrettl, M.; Bignell, E.; Kragl, C.; Sabiha, Y.; Loss, O.; Eisendle, M.; Wallner, A.; Arst, H.N., Jr.; Haynes, K.; Haas, H. Distinct roles for intra- and extracellular siderophores during Aspergillus fumigatus infection. PLoS Pathog. 2007, 3, 1195–1207. [Google Scholar] [CrossRef] [PubMed]
- Santamaria, F.; Reyes, F. Proteases produced during autolysis of filamentous fungi. Trans. Br. Mycol. Soc. 1988, 91, 217–220. [Google Scholar] [CrossRef]
- Latimer, P.; Pyle, B.E. Light scattering at various angles. Theoretical predictions of the effects of particle volume changes. Biophys. J. 1972, 12, 764–773. [Google Scholar] [CrossRef]
- Garcia-Rubio, R.; Monzon, S.; Alcazar-Fuoli, L.; Cuesta, I.; Mellado, E. Genome-Wide Comparative Analysis of Aspergillus fumigatus Strains: The Reference Genome as a Matter of Concern. Genes 2018, 9, 363. [Google Scholar] [CrossRef]
- Keller, N.P. Heterogeneity Confounds Establishment of “a” Model Microbial Strain. mBio 2017, 8, e00135-17. [Google Scholar] [CrossRef] [PubMed]
- Sugui, J.A.; Pardo, J.; Chang, Y.C.; Müllbacher, A.; Zarember, K.A.; Galvez, E.M.; Brinster, L.; Zerfas, P.; Gallin, J.I.; Simon, M.M.; et al. Role of laeA in the Regulation of alb1, gliP, Conidial Morphology, and Virulence in Aspergillus fumigatus. Eukaryot. Cell 2007, 6, 1552–1561. [Google Scholar] [CrossRef] [PubMed]
- Kowalski, C.H.; Beattie, S.R.; Fuller, K.K.; McGurk, E.A.; Tang, Y.-W.; Hohl, T.M.; Obar, J.J.; Cramer, R.A., Jr. Heterogeneity among Isolates Reveals that Fitness in Low Oxygen Correlates with Aspergillus fumigatus Virulence. mBio 2016, 7, e01515-16. [Google Scholar] [CrossRef] [PubMed]

| 14 h | 17 h | 20 h | 24 h | 48 h | 72 h | ||
|---|---|---|---|---|---|---|---|
| +Fe | pH ± SD | 5.69 ± 0 | 3.99 ± 0.04 | 3.62 ± 0.03 | 5.9 ± 0.44 | 8.63 ± 0.01 | 8.72 ± 0.05 |
| DW ± SD (g) | 0.09 ± 0.01 | 0.3 ± 0.01 | 0.6 ± 0.02 | 0.71 ± 0.02 | 0.49 ± 0.01 | 0.35 ± 0.05 | |
| final BS ± SD | 461 ± 36 | 880 ± 68 | 2011 ± 294 | 2752 ± 240 | 1887 ± 78 | 1582 ± 227 | |
| BS/DW ± SD | 5328 ± 369 | 2932 ± 227 | 3334 ± 564 | 3865 ± 379 | 3826 ± 92 | 4515 ± 590 | |
| −Fe | pH ± SD | 5.83 ± 0.02 | 5.27 ± 0.08 | 4.79 ± 0.06 | 4.13 ± 0.06 | 4.04 ± 0.03 | 4.04 ± 0.03 |
| DW ± SD (g) | 0.05 ± 0 | 0.09 ± 0 | 0.11 ± 0.01 | 0.14 ± 0.01 | 0.29 ± 0.01 | 0.27 ± 0.02 | |
| final BS ± SD | 170 ± 13 | 348 ± 37 | 500 ± 49 | 786 ± 78 | 1656 ± 44 | 1645 ± 78 | |
| BS/DW ± SD | 3234 ± 261 | 3896 ± 269 | 4514 ± 286 | 5763 ± 681 | 5718 ± 164 | 5995 ± 231 |
| Experiment 1 | Experiment 2 | Experiment 3 | ||
|---|---|---|---|---|
| +Fe | pH ± SD | 5.9 ± 0.44 | 5.63 ± 0.25 | 6.24 ± 0.1 |
| DW ± SD (g) | 0.71 ± 0.02 | 0.73 ± 0.01 | 0.73 ± 0.01 | |
| final BS ± SD | 2752 ± 240 | 2727 ± 132 | 2496 ± 236 | |
| BS/DW ± SD | 3865 ± 379 | 3752 ± 189 | 3415 ± 319 | |
| −Fe | pH ± SD | 4.13 ± 0.06 a | 4 ± 0 a | 4.43 ± 0.1 a |
| DW ± SD (g) | 0.14 ± 0.01 a | 0.11 ± 0.01 a | 0.14 ± 0.01 a | |
| final BS ± SD | 786 ± 78 a | 662 ± 66 a | 815 ± 41 a | |
| BS/DW± SD | 5763 ± 681 | 5848 ± 1079 | 5837 ± 368 |
| Gln Concentration | |||
|---|---|---|---|
| 20 mM | 10 mM | 5 mM | |
| pH ± SD | 5.9 ± 0.44 | 6.93 ± 0.06 a | 6.83 ± 0.06 b |
| DW ± SD (g) | 0.71 ± 0.02 | 0.35 ± 0.01 b | 0.16 ± 0 b |
| final BS ± SD | 2752 ± 240 | 1477 ± 40 b | 1052 ± 252 b |
| BS/DW ± SD | 3865 ± 379 | 4237 ± 30 | 6523 ± 1657 |
| AfS77 | ∆hapX | ∆srbA | ||
|---|---|---|---|---|
| +Fe | pH ± SD | 5.9 ± 0.44 | 5.43 ± 0.59 | 4.17 ± 0.06 c |
| DW ± SD (g) | 0.71 ± 0.02 | 0.71 ± 0 | 0.53 ± 0.03 c | |
| final BS ± SD | 2752 ± 240 | 2769 ± 192 | 2197 ± 196 a | |
| BS/DW ± SD | 3865 ± 379 | 3898 ± 256 | 4102 ± 146 | |
| −Fe | pH ± SD | 4.13 ± 0.06 | 4.2 ± 0.1 | 5.9 ± 0 |
| DW ± SD (g) | 0.14 ± 0.01 | 0.06 ± 0.01 c | 0.02 ± 0 c | |
| final BS ± SD | 786 ± 78 | 153 ± 6 c | 89 ± 14 b | |
| BS/DW ± SD | 5763 ± 681 | 2594 ± 328 | 3573 ± 523 |
| AfS77 | A1160p+ | AfS35 | Af293 | |||
|---|---|---|---|---|---|---|
| 24 h | +Fe | pH ± SD | 5.9 ± 0.44 | 4.9 ± 0.26 | 3.5 ± 0.06 | 5.65 ± 0.31 |
| DW ± SD (g) | 0.71 ± 0.02 | 0.69 ± 0 c | 0.6 ± 0.03 c | 0.04 ± 0.01 c | ||
| final BS ± SD | 2752 ± 240 | 2845 ± 322 c | 2146 ± 47 b | 271 ± 116 c | ||
| BS/DW ± SD | 3865 ± 379 | 4119 ± 483 | 3596 ± 229 | 6088 ± 1507 | ||
| −Fe | pH ± SD | 4.13 ± 0.06 | 3.5 ± 0 a | 3.82 ± 0.08 | 6.09 ± 0.08 c | |
| DW ± SD (g) | 0.14 ± 0.01 | 0.09 ± 0.01 a | 0.11 ± 0 | NA d | ||
| final BS ± SD | 786 ± 78 | 964 ± 105 | 631 ± 42 | 109 ± 35 b | ||
| BS/DW ± SD | 5763 ± 681 | 10,990 ± 1862 | 5696 ± 411 | NA d | ||
| 48 h | +Fe | pH ± SD | 8.63 ± 0.01 | 8.76 ± 0.04 | 8.68 ± 0.06 | 6.71 ± 0.11 c |
| DW ± SD (g) | 0.49 ± 0.01 | 0.39 ± 0.01 c | 0.48 ± 0.02 | 0.62 ± 0.03 c | ||
| final BS ± SD | 1887 ± 78 | 2207 ± 116 | 1962 ± 263 | 1583 ± 203 | ||
| BS/DW ± SD | 3826 ± 92 | 5613 ± 342 | 4130 ± 678 | 2538 ± 280 | ||
| −Fe | pH ± SD | 4.04 ± 0.03 | 4.12 ± 0.02 | 3.45 ± 0.03 c | 5.23 ± 0.2 c | |
| DW ± SD (g) | 0.29 ± 0.01 | 0.17 ± 0.01 c | 0.18 ± 0.01 c | 0.11 ± 0.02 c | ||
| final BS ± SD | 1656 ± 44 | 1404 ± 247 | 1172 ± 62 | 515 ± 208 c | ||
| BS/DW ± SD | 5718 ± 164 | 8330 ± 1954 | 6644 ± 388 | 4422 ± 952 |
Publisher’s Note: MDPI stays neutral with regard to jurisdictional claims in published maps and institutional affiliations. |
© 2022 by the authors. Licensee MDPI, Basel, Switzerland. This article is an open access article distributed under the terms and conditions of the Creative Commons Attribution (CC BY) license (https://creativecommons.org/licenses/by/4.0/).
Share and Cite
Bauer, I.; Abt, B.; Yap, A.; Leuchtle, B.; Haas, H. Online Biomass Monitoring Enables Characterization of the Growth Pattern of Aspergillus fumigatus in Liquid Shake Conditions. J. Fungi 2022, 8, 1013. https://doi.org/10.3390/jof8101013
Bauer I, Abt B, Yap A, Leuchtle B, Haas H. Online Biomass Monitoring Enables Characterization of the Growth Pattern of Aspergillus fumigatus in Liquid Shake Conditions. Journal of Fungi. 2022; 8(10):1013. https://doi.org/10.3390/jof8101013
Chicago/Turabian StyleBauer, Ingo, Beate Abt, Annie Yap, Bernd Leuchtle, and Hubertus Haas. 2022. "Online Biomass Monitoring Enables Characterization of the Growth Pattern of Aspergillus fumigatus in Liquid Shake Conditions" Journal of Fungi 8, no. 10: 1013. https://doi.org/10.3390/jof8101013
APA StyleBauer, I., Abt, B., Yap, A., Leuchtle, B., & Haas, H. (2022). Online Biomass Monitoring Enables Characterization of the Growth Pattern of Aspergillus fumigatus in Liquid Shake Conditions. Journal of Fungi, 8(10), 1013. https://doi.org/10.3390/jof8101013

